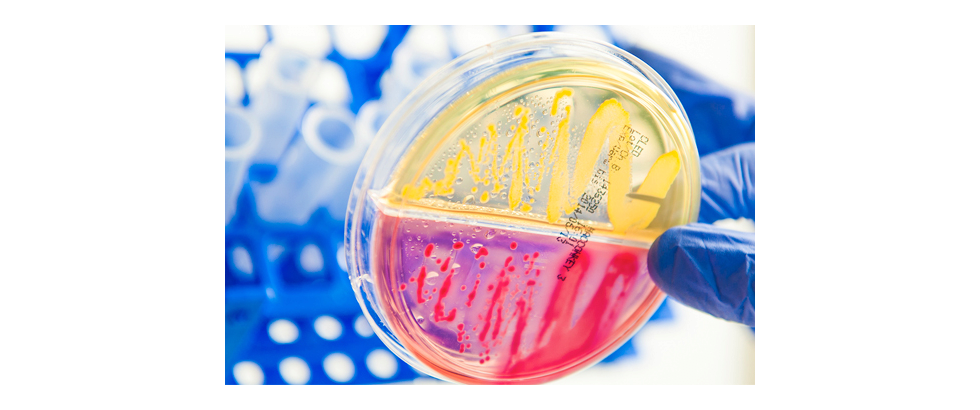

Urologische Privatpraxis Prof. Dr. Oliver Reich
wir begrüßen Sie herzlich auf der Internetseite der urolgischen Privatpraxis
Prof. Dr. med. Oliver Reich,
Facharzt für Urologie
Andrologie
Med. Tumortherapie
Prof. Dr. med. O. Reich
Wir freuen uns, dass
Prof. Dr. med. O. Reich
das Team der Urologie seit 1.1.2022 verstärkt.
Prof. Reich war zuvor als Chefarzt der Urologischen Klinik am Klinikum Harlaching in München tätig und ist in Unterhaching aufgewachsen und zur Schule gegangen.
Er ist spezialisiert auf endoskopische Eingriffe.
Online-Terminvereinbarung
Unter folgendem Link können PRIVATPATIENTEN und SELBSTZAHLER online einen Untersuchungstermin vereinbaren.